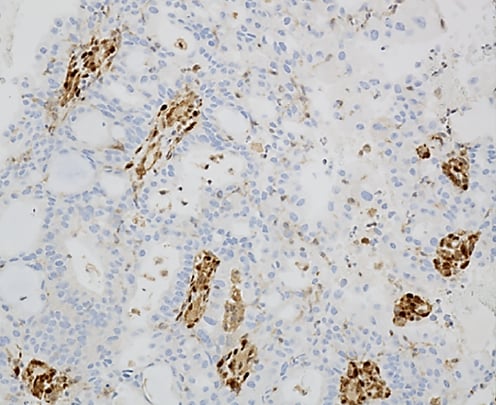
看懂子宫内膜样癌病理报告:FIGO分级与关键基因(PTEN/TP53/MMR)深度解析 5 PTEN表达丢失

引言:读懂您的病理报告
当您或您的家人拿到一份子宫内膜样癌的病理报告时,上面密密麻麻的专业术语,如“FIGO分级”、“细胞异型性”、“免疫组化”等,是否让您感到困惑和焦虑?这份报告是诊断和制定后续治疗方案的基石。理解其中的关键信息,对于选择最合适的治疗方法,包括靶向治疗和免疫治疗,至关重要。本文将用通俗易懂的语言,带您一步步解读子宫内膜样癌的病理报告。
一、什么是子宫内膜样癌?
子宫内膜样癌是最常见的子宫内膜癌类型,是一种起源于子宫内膜腺体的恶性肿瘤。在显微镜下,病理医生会观察到肿瘤细胞形成了类似正常子宫内膜的腺体结构,但这些结构在形态和排列上都表现出异常,即所谓的“异型性”。
二、病理特征:医生在显微镜下看到了什么?
病理医生会从“结构”和“细胞”两个层面来评估肿瘤的恶性程度。
1. 结构异型性
正常的子宫内膜腺体排列有序,而癌变的腺体则会变得拥挤、混乱,形成各种不规则的结构:
- 腺体密集/背靠背:癌变腺体紧密地挤在一起,中间几乎没有正常的间质组织。
- 筛状结构:多个腺体融合成一片,形成像筛子一样的孔洞结构。

图示:癌组织中密集、形态不一的腺管结构

图示:腺体“背靠背”紧密排列
2. 细胞异型性
除了结构混乱,癌细胞本身也会发生变化,主要看细胞核的形态:
- 1级(轻度异型):细胞核形态还比较规则,接近正常细胞。
- 2级(中度异型):细胞核大小不一,形态开始不规则。
- 3级(重度异型):细胞核显著增大、形态怪异,是恶性程度高的表现。

图示:中度异型的细胞核,可见不规则性和染色质团块
三、核心指标:FIGO分级如何影响治疗?
FIGO(国际妇产科联盟)分级是评估子宫内膜样癌恶性程度和预后的金标准,主要依据肿瘤中“实性生长”区域所占的比例。简单来说,腺体结构越少、实性成分越多,分级就越高,肿瘤的侵袭性也越强。
- FIGO 1级(G1,低级别):肿瘤分化好,实性生长区域 ≤5%。
- FIGO 2级(G2,低级别):肿瘤中度分化,实性生长区域占 6%-50%。
- FIGO 3级(G3,高级别):肿瘤分化差,实性生长区域 >50%。
特别注意:如果肿瘤细胞普遍存在重度异型(3级核),即使实性成分不多,分级也可能会被提升一级。FIGO分级直接关系到治疗方案的选择,高级别(G3)肿瘤通常需要更积极的治疗,如范围更大的手术和辅助化疗。

图示:FIGO 3级肿瘤,大部分区域为实性生长模式
四、免疫组化(IHC):揭示肿瘤的“分子身份证”
免疫组化(IHC)检测通过染色来观察肿瘤细胞中特定蛋白质的表达情况,这些蛋白质就像肿瘤的“分子身份证”,能提供诊断、分型、预后判断和指导用药的关键信息。
- ER/PR(雌孕激素受体):大多数低级别子宫内膜样癌表达ER和PR,提示肿瘤生长可能依赖激素,对内分泌治疗反应较好。
- p53:这是一种重要的抑癌基因。p53的表达模式可以提示是否存在TP53基因突变。野生型(正常)p53表达不一,而突变型通常表现为“全阳性”或“全阴性”。p53突变往往与高级别、预后差的肿瘤相关。
- PTEN:这是另一个关键的抑癌基因。PTEN蛋白表达缺失是子宫内膜样癌中最常见的分子事件之一,见于超过半数的病例。这一信息可能与某些靶向治疗药物的疗效相关。
- MMR蛋白(MLH1, PMS2, MSH2, MSH6):这组蛋白负责修复DNA复制过程中的错误。当它们中的任何一个表达缺失时,称为错配修复缺陷(dMMR)或微卫星不稳定性高(MSI-H)。dMMR/MSI-H状态的肿瘤对免疫检查点抑制剂(如PD-1/PD-L1抑制剂)治疗的响应率更高。因此,MMR检测对于是否选择免疫治疗至关重要。
图示:免疫组化显示肿瘤细胞中PTEN蛋白表达丢失(不着色),而周围正常细胞仍表达(棕色)
结论
看懂子宫内膜样癌的病理报告,是患者参与治疗决策的第一步。从FIGO分级到p53、PTEN和MMR等分子标志物,每一个信息都为医生描绘出肿瘤的全貌,从而制定出最精准、个体化的治疗策略。特别是分子分型结果,直接关系到是否能从靶向治疗或免疫治疗中获益。如果您对报告中的内容有任何疑问,或想了解更多关于靶向药、免疫治疗药物的价格和购买渠道,建议及时与您的主治医生沟通,或通过专业的医疗服务平台(如MedFind)进行咨询。
